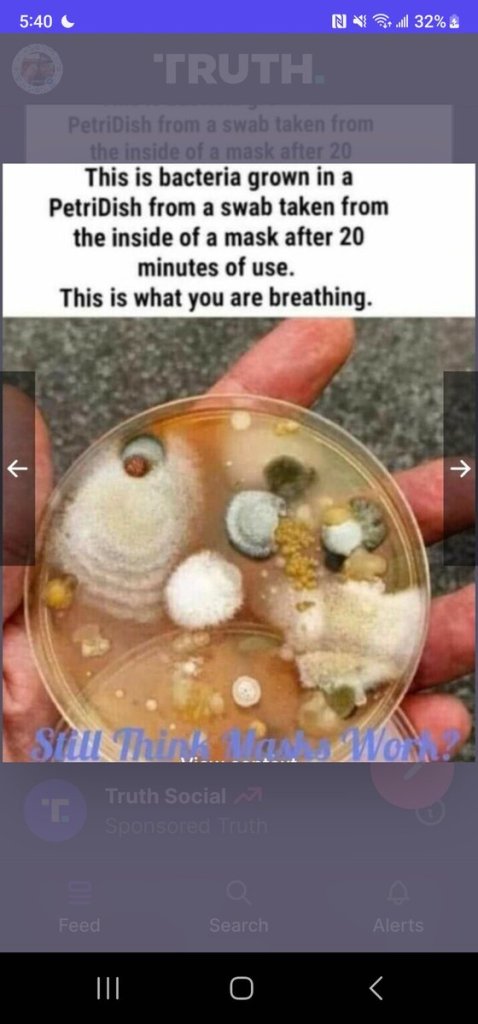

Well, it’s been a very full week and if it wasn’t for the fact that we have a snow day today and the base is closed, you probably wouldn’t be getting an issue on Thursday at all. Today, being Wednesday. They closed the base as we’re in the midst of getting about 8 inches of snow. The snow is coming down pretty heavy right now, about an inch an hour. And it’s supposed to keep going until about 8 pm tonight.
Anyway, it’s going to be close as it is, so let’s get to the laughter.




A Blonde frantically calls the fire department to report a fire in the neighbourhood.
The dispatcher asks, “Well, lady how do we get there?”
Confused she replies, “Don’t you still have those little red fire engines?”



Marriage One Liners…..
Whether a man winds up with the nest egg or a goose egg depends a lot on the kind of chick he marries.
Trouble in marriage often starts when a man gets so busy earning his salt that he forgets his sugar.
Too many couples marry for better or for worse, but not for good.
When a man marries a woman, they become one, but the trouble starts when they try to decide which one.
If a man has enough “horse sense” to treat his wife like a thoroughbred, she will never be an old nag.
On anniversaries the wise husband always forgets the past…but never the present.
A foolish husband remarks to his wife: “Honey, you stick to the washing, ironing, cooking, and scrubbing. No wife of mine is going to work.
The bonds of matrimony are a good investment only when the interest is kept up.
Many girls like to marry a military man–he can cook, sew, make a bed, and is in good health…and he’s already used to taking orders.



A fellow is feeling a little frisky, but true to his wife, goes home.
He finds her sound asleep in the bed with her mouth wide open, so he gets two aspirin and drops them in her mouth.
She starts to choke, but recovers and asks, “What did you put in my mouth?”
He says, “Two aspirin.”
She replies, “BUT I DON’T HAVE A HEADACHE!”
He says, “That’s all I wanted to hear…”





Only the best for our security teams.



My son Mark was only 5 feet, 8 inches tall when he left for college in the fall. He worked through the Christmas holidays and didn’t return home again until the February break.
When he got off the plane, I was stunned at how much taller he looked.
Measuring him at home, I discovered he now stood at 5 feet, 10¹/² inches.
My son was as surprised as I. “Couldn’t you tell by your clothes that you’d grown?” I asked him.
“Since I’ve been doing my own laundry,” he replied, “I just figured everything had shrunk.”



Four U.S. Presidents are caught in a tornado, and off they spin to Oz. After frightening trials and tribulations, they finally make it to the Emerald City and come before the Great Wizard.
“WHAT BRINGS YOU BEFORE THE GREAT WIZARD? WHAT DO YOU WANT?”
Jimmy Carter steps forward timidly: “I had a terrible time with Iran, so I’ve come for some courage.”
“No problem,” says the Wizard. “WHO IS NEXT?”
Ronald Reagan steps forward and says, “Well… Well… Well… I need a brain.”
“Done,” says the Wizard. “WHO COMES NEXT BEFORE THE GREAT WIZARD?”
Up steps George Bush sadly: “I’m told by the American people that I need a heart.”
“I’ve heard that it’s true,” says the Wizard. “Consider it done.”
Then there is a great silence.
Bill Clinton just stands there, looking around, but doesn’t say a word.
Irritated, the Wizard finally asks, “WHAT BRINGS YOU TO THE EMERALD CITY?”
“Is Dorothy around?”



Little Johnny’s mother decided to tell him all about making babies, so she had “the talk” with him.
Afterwards Little Johnny just sat there silently for awhile.
“Do you understand?” his mother asked.
“Yes,” replied Little Johnny.
“Do you have any questions?” asked his Mother.
“Yes, how about little kittens and puppies?” asked Little Johnny.
“In exactly the same way as with babies”, answered his Mom.
“Wow!” Little Johnny exclaimed. “My daddy will fuck ANYTHING!”





Our over watch sharpshooter is WAY over watch!



A pastor giving a children’s sermon on vestments asked, “Why do think I wear this collar?”
One kid answered, “Because it kills fleas and ticks for 30 days?”

Picture taken from the same place at the same time each month for a year.


When the offering was processed the following Sunday, he found that his card had been returned. Added to it was this cryptic message, “Genesis 3:10.”
Reaching for his Bible to check out the citation, he broke up in gales of laughter.
Genesis 3:10 reads: “I heard your voice in the garden and I was afraid for I was naked.”



There was this little grey mouse that worked in a factory pulling wires through conduits and every evening after work he would stop in at the neighborhood bar for a beer or two before going home.
He was unmarried and well liked by the bartender, he always cashed his paycheck on Friday night and had more than two beers.
This particular Friday night the mouse was setting at the bar having a beer and this strikingly beautiful long necked lady giraffe comes in and takes a seat at the end of the bar.
The mouse looks her over and she is checking out the mouse. The mouse told the bartender to give her a drink and soon they are seated together.
The bar fills up and the bartender loses track of them.
The bartender can’t wait to hear how it went with the mouse and giraffe, but on Monday the mouse don’t show, nor on Tuesday or Wednesday, but on Thursday he comes in, his fur all roughed up, his eyes bloodshot, and his tail just dragging the floor.
He climbs up on a stool, orders a beer and as the bartender set it down, the bartender asks how it went, and why are you looking like you were run over by a Mack truck?
The mouse answers, it was just wonderful.
The bartender says what caused you to look so bad, the mouse said “between the kissing and the loving, I’ve run 900 miles.”



Once upon a time, in Colorado, the chief of an Indian tribe, I believe it was the Navajos, had a very beautiful daughter. And she was of marrying age. And many, many braves were wanting the daughter’s hand in marriage.
Well, being a wise chief, he decided that he wanted his daughter to marry the bravest and strongest and wisest brave of the bunch. So he held a contest. All the eligible bachelors were to go hunting and the brave that brought back the biggest and best catch would be given the chief’s daughter in marriage.
A lot of braves turned out for this event. On Monday morning they all set out, bows and arrows in hand. Well, on Tuesday afternoon, all the braves had brought their killings in except for three: Running Bear,Sitting Bull, and Falling Rock.
On Wednesday morning, Running Bear brought in a really big black bear,weighing 480 pounds and 7 foot in length. The chief was quite impressed. This was the best killing of all so far. But, of course,they had to wait for the remaining two before he could award his daughter to Running Bear.
Well, on Wednesday night, Sitting Bull brought back a really, really big cougar, even bigger than the black bear that Running Bear had come home with. The cougar weighed 620 pounds and was 7 1/2 feet long. Clearly,Sitting Bull was about to win the chief’s daughter’s hand in marriage. Excitement rose within the camp. Everyone was pretty sure that Falling Rock couldn’t top Sitting Bull’s catch!
Thursday came and went ….. Friday came and went ….. Saturday came and went ….. The weeks turned into months and the months into years,and still Falling Rock did not return.
It was obvious, the chief couldn’t wait forever for Falling Rock to return. So he granted his daughter to Sitting Bull and they lived happily ever after, and the tribe no longer waited for the wayward brave, but they did keep their eyes open when out on the trails. And even today you will still see in Colorado those signs that say, “Watch for Falling Rock.”









My mom got mad at my dad the other day and went shopping to relieve her irritation…
When she returned home she informed him that she had purchased ten new dresses…
“Ten!” he hollered, “What could any woman want with ten new dresses??”
My mom calmly replied, “Ten new pairs of shoes.”



There’s a new health study that was just completed that claims having sex decreases your chances of getting a cold.
The more sex you have, the less chance you’ll have of catching a cold.
Can you just picture how it’s gonna be in office’s across the country this winter, every time a woman sneezes there’ll be some guy saying, “Hey, I got something for that.”



My 17 year old daughter, Steph who had just received her provisional diving licence offered to drive us to church.
After a wild ride, we finally reached our destination.
Steph’s mother got out of the car and said, “Thank you.”
“Anytime,” Steph replied.
As my wife slammed the door, she said, “I wasn’t talking to you. I was talking to God.”

If you want to impress me, don’t send me nude pics, send me pics of your garden so I know we’re still gonna eat when all this stuff starts really hitting the fan…



Don’t trust or take medical advice from anyone who would LEAVE YOUR ASS IN AFGHANISTAN!!!

The National Oil Reserve is for emergency use only, not for leadership incompetence!



If BLM expects reparations for what happened 200 years ago, why aren’t they offering to pay for what they broke, burned down and destroyed over the last 3 years?




A TV can insult your intelligence, but nothing rubs it in like a computer.



How do you get a one-armed blonde out of a tree?
Wave to her.





Boy, ain’t that the…

Tombstone:
In a cemetery in Hartscombe, England:
On the 22nd of June,
Jonathan Fiddle
Went out of tune.



A noted biologist, who had been studying little green frogs in a swamp, was stumped.
The frog population, despite efforts at predator control, was declining at an alarming rate.
A chemist at a nearby college came up with a solution: The frogs, due to a chemical change in the swamp water, simply couldn’t stay coupled long enough to reproduce successfully.
The chemist then brewed up a new adhesive to assist the frogs’ togetherness, which included one part sodium.
It seems the little green frogs needed some monosodium glue to mate.


That’s me…old as dirt.

Dan married one of a pair of identical twin girls. Less than a year later, he was in court filing for a divorce.
“OK,” the judge said, “Tell the court why you want a divorce.”
“Well, your honour,” Dan started, “Every once in a while my sister in law would come over for a visit, and because she and my wife are so identical looking, every once in a while I’d end up making love to her by mistake.”
“Surely there must be some difference between the two women,” the judge said.
“You’d better believe there is a difference, your honour. That’s why I want the divorce.” He replied.



And that’s it my friends. May your days be blessed by God and filled with Love and Happiness.













